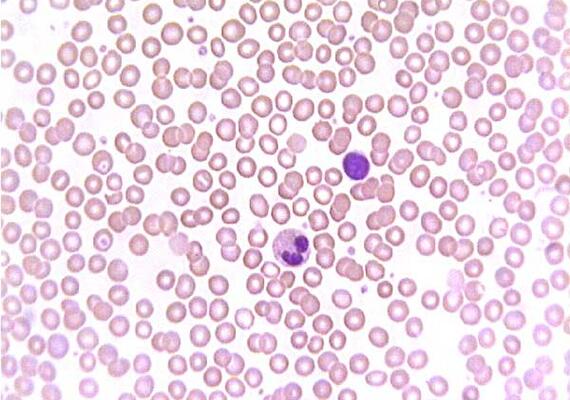
Blood Smear- Image Credit to siumed.edu

Blood Smears & Syringes

Materials Needed
To practice holding and using a syringe you will need some materials from your swag bags. You can practice the techniques in the video below with the 3ml, 10ml, and 20ml syringes in your swag bags. Please see the image on the right for reference.
Enjoy practicing using a syringe!
Using a Syringe
Watch the video below to learn how to properly hold a syringe!

Smearing
Blood smears are a technique that we use to analyze blood. We make a blood smear by putting a drop of blood on a microscope slide and using a special technique to spread the blood evenly on the slide, so that under a microscope, the blood cells can be seen as a single layer of cells. Once the blood dries on the slide, we use special stains that make the blood cells easier to see and differentiate! Blood smears enable us to look at the size, shape, and number of different types of blood cells. Although many blood tests today use computerized machines, blood smears must be performed by a laboratory technician. Making a good quality blood smear is very important, but it takes a lot of practice and finesse!
Image credit: https://www.agric.wa.gov.au/sites/gateway/files/Step%206.jpg

Blood Recipe - Get Cooking
Since you cannot and should not use real blood to practice making blood smears today, we recommend making fake blood to help you nail the blood smear technique!
Fake Blood Recipe:
3/4 cup corn syrup
1/4 cup water
1/2 teaspoon red food coloring
5 drops blue food coloring
2 drops green food coloring
1 tablespoon corn starch

Smear Materials
To practice doing blood smears with your fake blood you will need some materials from your swag bags. For this activity you will need glass microscope slides. These slides will be found in your pencil case that you will have opened with parent/guardian supervision/permission while practicing your suturing skills on equine day. Inside the pencil case, the glass microscope slides will be found in a white envelope wrapped in gauze roll to prevent them from breaking. You will also need your 3ml syringe to deposit drops of your fake blood onto the slide. Please see the image to the right for reference.
Enjoy practicing your blood smears!
Blood Smears Preparation
A blood smear is where you put a drop of blood on a microscope slide and you utilize a specific technique so that you can smear the blood drop. Your finished product should have a single layer of cells on the slide, that allows you to look under the microscope for abnormalities. Learn how to correctly make a blood smear in the video below!
What do Blood Smears Tell Us?
This image was made by doing the technique shown above (blood smear preparation), then staining the slide with pink and purple stains and looking at the slide with a microscope. Microscopes help us to see blood cells, which are much too small to see with our naked eye. Most of the cells in the slide are red blood cells (RBCs). They look like pink discs. There are two cells on our slide that have stained very purple. These are white blood cells (WBCs). There are different kinds of white blood cells in our body. This image shows a neutrophil and a lymphocyte. There are also smaller specks on our slide that aren't nearly the same size as the WBCs and RBCs. These are called platelets. They play an important role in blood clotting.
Image Credit to siumed.edu.

Technique Tips
Blood smears are a hard skill to master. If you are struggling, look at the graphic to the left. Do any of your slides look similar to the examples in the graphic? Certain errors create characteristic blood smear patterns. Look at the common reasons for an improper smear and try and adjust your technique!
Let us know if you have any questions or need any help! This skill takes a lot of practice!
Image credit: https://i.pinimg.com/originals/a5/f3/44/a5f344fb5f4ab078188d45f8eeaba575.jpg